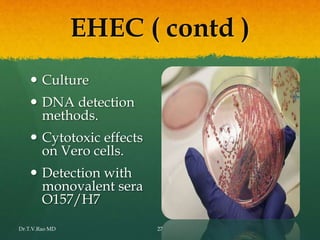
EHEC ( contd )
 Culture
 DNA detection
methods.
 Cytotoxic effects
on Vero cells.
 Detection with
monovalent sera
O157/H7
Dr.T.V.Rao MD 27

This document discusses Escherichia coli (E. coli) as both a commensal bacteria normally found in the intestines and an opportunistic pathogen. It describes some of the characteristics of E. coli, including that there are many strains with different virulence properties. Key pathogenic strains discussed are enterotoxigenic E. coli, enteropathogenic E. coli, enterohemorrhagic E. coli, and enteroaggregative E. coli, each known to cause specific gastrointestinal diseases. E. coli is also a common cause of urinary tract infections. The document provides details on laboratory identification and diagnosis of E. coli from various clinical specimens.